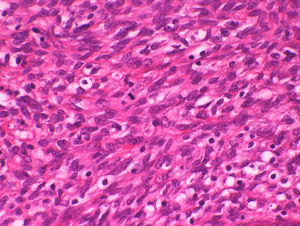
En el estroma se observan ocasionales figuras mitóticas, predominantemente en las zonas de los «collaretes». (HE×400).

El adenosarcoma de útero es una neoplasia rara y representa aproximadamente el 8% de todos los sarcomas uterinos. Está relacionado con antecedentes de tratamiento con tamoxifeno y con radiación pélvica. La clínica más característica es la de una lesión polipoide recidivante, siendo habitual que la paciente ya haya tenido algunas biopsias previas por ese mismo motivo, en las cuales no haya podido llegarse a un diagnóstico acertado y definitivo. Incluso puede haber llegado a darse un diagnóstico erróneo, de los cuales el más frecuente es el de un pólipo cervical. La lesión consta de un componente glandular benigno creciendo inmerso en un estroma sarcomatoso.
Presentamos el caso de una mujer de 53 años con una lesión polipoide uterina. Tras los estudios macroscópico, microscópico e inmunohistoquímico se llegó al diagnóstico de adenosarcoma mülleriano de útero. Se trata de una neoplasia de bajo grado y buen pronóstico, pero que recidiva en un alto porcentaje de casos (25-40%).
El tratamiento es la histerectomía total simple con doble anexectomía, seguida o no de radioterapia postoperatoria, aunque en pacientes jóvenes, que no tienen el deseo genésico cumplido, al ser una neoplasia de bajo grado, se han descrito casos en los que se ha optado por un tratamiento conservador.
De todas formas, no hay que olvidar que se trata de un tumor maligno y que también se han descrito casos de fallecimiento por esta entidad a causa de metástasis abdominales o de otro tipo, por lo que somos de la opinión de que la mejor y más segura opción terapéutica es la histerectomía.
Uterine adenosarcoma is a rare neoplasm constituting only around 8% of all uterine sarcomas. This tumor is associated with tamoxifen therapy and pelvic radiation. The most characteristic clinical feature is a recurrent cervical polypoid lesion. Patients have often had previous biopsies for the same reason, but without an accurate diagnosis. Furthermore, a mistaken diagnosis may have been made, the most common being cervical polyp. Uterine adenosarcoma consists of neoplastic glands with a benign appearance and a sarcomatous stroma.
We report the case of a 53-year-old woman with a uterine polypoid lesion. After macroscopic, microscopic and immunohistochemical studies, the diagnosis was a uterine Müllerian adenosarcoma, which is a low-grade neoplasm with good prognosis, but with a high percentage of recurrences (25%-40%).
Treatment is simple hysterectomy with double adnexectomy, with the option of subsequent postoperative radiotherapy. However, because this tumor is a low-grade neoplasm, a more conservative approach has sometimes been adopted in some young patients without children.
This tumor is malignant, however, and mortality from abdominal or other types of metastases has been reported. Therefore, we believe that the most appropriate and safest therapeutic option is hysterectomy.
Los adenosarcomas de útero son neoplasias raras (en nuestro servicio se han diagnosticado 3 en los últimos 5 años). El rango etario de aparición es muy amplio, pudiendo darse desde los 10 a los 90 años, aunque es más frecuente en mujeres posmenopáusicas. Está relacionado con antecedentes de tratamiento con tamoxifeno y con radiación pélvica. La clínica más característica es la de una lesión polipoide recidivante, siendo habitual que la paciente tenga algunas biopsias previas por este mismo motivo, en las cuales no se haya podido establecer un diagnóstico acertado y definitivo.
Descripción del casoSe trata de una mujer de 53 años, que presenta una lesión polipoide uterina de comportamiento recidivante. La paciente ya había sido sometida a 2 biopsias previas, en las cuales no se pudo establecer un diagnóstico acertado. La primera fue en diciembre del 2006 y la segunda en febrero del 2007. En febrero del 2008 (un año después) se realiza la biopsia que nos permite, finalmente, llegar al diagnóstico definitivo. A tenor de ese diagnóstico, se le practica una histerectomía con doble anexectomía. Tras la operación quirúrgica y hasta la actualidad (5 años después), la paciente se ha mantenido sin signos de recidiva.
La biopsia recibida en primer lugar se corresponde con un fragmento de tejido de morfología polipoide, liso, blanquecino con áreas violáceas y que mide 5×2×1cm. En la posterior pieza de histerectomía, a la apertura del útero, se reconoce una lesión multipolipoide, de aspecto similar al de la biopsia previa, que ocupa casi toda la cavidad uterina y que depende del fundus (fig. 1). La lesión presenta unas dimensiones máximas de 5×3×3cm y se observa en el ápice inferior (que casi protruye por el orificio endocervical) un área congestivo-hemorrágica.
Histológicamente, se observa la morfología polipoide descrita en el examen macroscópico (fig. 2). Lo que más llama la atención es el predominio estromal de la lesión, siendo además el estroma muy celular (fig. 3). En él se evidencian áreas de atipia, aunque estas son muy raras. Además, se observan glándulas endometriales bastante anodinas, con epitelio de tipo proliferativo seudoestratificado, sin atipia. Característicamente, el estroma se densifica alrededor de las glándulas, abrazándolas (collaretes) (fig. 4), y en esas zonas de densificación se pueden observar algunas mitosis (máximo 1-2/10 c.g.a.) (fig. 5). Asimismo, en el estroma, ocasionalmente, se observan focos de metaplasia escamosa. El anclaje en la pared uterina es bien delimitado y no invade el miometrio. No se observan áreas de diferenciación heteróloga ni de sobrecrecimiento estromal. Inmunohistoquímicamente, las células estromales muestran positividad para RE y RP, siendo negativas para caldesmón, actina y desmina; el índice proliferativo con ki-67 es del 20%.
Con estos resultados, el diagnóstico fue de adenosarcoma mülleriano de útero.
DiscusiónLos adenosarcomas de útero son tumores muy poco habituales, que representan aproximadamente el 8% de todos los sarcomas uterinos1. Aunque pueden darse a casi cualquier edad, son más frecuentes en mujeres posmenopáusicas (la media de edad se sitúa en 58 años1), siendo muy raros en adolescentes; se debe destacar un caso descrito en una niña de 10 años2. Los factores de riesgo asociados son los estados hiperestrogénicos, la terapia con tamoxifeno y la radioterapia pélvica previa. En nuestro caso, la paciente no había recibido ninguno de los tratamientos mencionados.
Clínicamente, los síntomas son bastante inespecíficos, pudiendo haber sangrado vaginal, útero agrandado, protrusión a través del orificio cervical, dolor pélvico, etc. Pero la clínica más característica es la de una lesión polipoide recidivante biopsiada en varias ocasiones, en las cuales no pudo llegarse a un diagnóstico definitivo. Incluso puede haber llegado a darse un diagnóstico erróneo, de los cuales el más frecuente es el de un pólipo cervical3,4. Estos tumores, ocasionalmente, pueden darse fuera del útero (ovario y trompa de Falopio)5.
Macroscópicamente, se trata de lesiones polipoides o multipolipoides que pueden llegar a protruir a través del orificio endocervical y que también pueden llegar a ocupar toda la cavidad uterina, como ocurre en nuestro caso.
Microscópicamente, el tumor consta de un componente glandular benigno creciendo inmerso en un estroma sarcomatoso1,6,7. En el seno de la lesión son muy habituales las hendiduras (similares a las observadas en los tumores phyllodes de la mama) y en superficie se suelen formar proyecciones papilares del estroma, revestidas por epitelio endometrial de características típicas. El epitelio glandular y superficial es anodino (solo ocasionalmente puede presentar rasgos hiperplásicos con o sin atipia), siendo de aspecto inactivo o, como en nuestro caso, proliferativo; no es raro observar además otros tipos de epitelio, tales como mucinoso, escamoso, secretor o de célula clara. A menudo, se observan glándulas en las zonas de invasión miometrial de los adenosarcomas, lo que sugiere que, a pesar del aspecto anodino del mismo, este componente es parte activa de la neoplasia. La característica más llamativa de estos tumores es el componente estromal, manifiestamente predominante; suele mostrar el aspecto de un sarcoma de bajo grado cuya atipia citológica es variable aunque, por lo general, es baja o moderada. Característicamente, el estroma se densifica alrededor de las glándulas, rodeándolas a modo de collarete y en esas zonas de densificación se pueden observar algunas mitosis (habitualmente no más de 2-4/10 c.g.a.). El anclaje en la pared uterina suele ser bien delimitado, aunque en ocasiones invade ampliamente el miometrio, conllevando en estos casos un peor pronóstico. Pueden observarse áreas de diferenciación heteróloga3 (músculo esquelético, lipoblastos, cartílago, etc.) o de sobrecrecimiento estromal3,8 (una porción del estroma de mayor grado, que prolifera de una manera desproporcionada) y ambos factores también son datos de mal pronóstico, aunque hay autores que manifiestan que la presencia de áreas de diferenciación heteróloga no es un factor de mal pronóstico6. El sobrecrecimiento estromal está presente en aproximadamente el 10% de los adenosarcomas y se diagnostica cuando el componente sarcomatoso ocupa el 25% o más del volumen tumoral total; de forma típica, el componente epitelial está ausente en estas zonas y el componente mesenquimal es de alto grado.
Inmunohistoquímicamente, la porción estromal es positiva para RE, RP, WT1, actina y desmina, aunque en nuestro caso estas 2 últimas no lo fueron. También se ha descrito positividad para CD109,10; en relación con este último marcador, Mikami et al. comentan que la positividad de CD10 es una de las características de las células neoplásicas derivadas del sistema mülleriano10. La porción epitelial es positiva para los marcadores de glándulas uterinas convencionales. Se ha descrito una positividad menor para los marcadores estromales en las áreas de sobrecrecimiento estromal8.
En este tipo de lesiones es esencial realizar un adecuado diagnóstico diferencial, principalmente con otros tumores müllerianos mixtos, como el adenofibroma, que posee componentes epitelial y mesenquimal benignos, de tal forma que el estroma es hipocelular, carece de atipia citológica y su índice mitótico es bajísimo, menor de 2 mitosis/10 c.g.a.3; el carcinofibroma, de componente epitelial maligno y mesenquimal benigno, y el carcinosarcoma, que posee componentes epitelial y mesenquimal malignos; estos 2 últimos tumores se diferencian relativamente bien reconociendo las áreas de malignización del componente epitelial. También hay que diferenciarlo del adenomioma polipoide atípico, cuyo componente estromal muestra músculo liso prominente (muy raro en el adenosarcoma) y del pólipo endometrial o endocervical convencional, que suele ser de menor tamaño, con un estroma menos celular y más fibroso, sin atipia (por lo general), con índice mitótico muy bajo, ausencia de estroma periglandular condensado y ausencia de arquitectura papilaroide, sin hendiduras o espacios. Por último, hay que destacar también el sarcoma del estroma endometrial, que también puede presentar un componente glandular, pero estas glándulas no forman parte del tumor, observándose en la periferia y estando ausentes en el seno; en los casos raros en los que se observa componente epitelial (sarcoma del estroma endometrial con diferenciación glandular o diferenciación de los cordones sexuales), este no se encuentra abrazado por el componente estromal y además no se observa la arquitectura típica del adenosarcoma (hendiduras, estructuras papilares estromales en superficie, etc.).
Como ya se ha comentado, se trata de una neoplasia de bajo grado y buen pronóstico6, pero que recidiva en un alto porcentaje de casos (25-40%). El pronóstico depende de factores como la diferenciación heteróloga, el sobrecrecimiento estromal y el número de mitosis3.
El tratamiento es la histerectomía total simple con doble anexectomía, seguida o no de radioterapia postoperatoria, aunque en pacientes jóvenes, que no tienen el deseo genésico cumplido, al ser una neoplasia de bajo grado, se han descrito casos en los que se ha optado por un tratamiento conservador; el objetivo de esta actitud conservadora es preservar la fertilidad de la paciente y que en un futuro pueda tener descendencia. Así, Abu et al. describen el caso de una paciente de 27 años, nuligesta, diagnosticada de adenosarcoma uterino, cuyo tratamiento fue la observación. Asimismo hablan de que se trata de un dilema clínico en estos casos1.
De todas formas, no hay que olvidar de que se trata de un tumor maligno (aunque sea de bajo grado) y que también se han reportado casos de fallecimiento por esta entidad a causa de metástasis abdominales o de otro tipo. Así, por ejemplo, Hariri describe el caso de una paciente de 73 años diagnosticada de adenosarcoma uterino que, a pesar de ser tratada con histerectomía y doble anexectomía, y recibir radioterapia vaginal postoperatoria, falleció 7 meses después por metástasis abdominales7. Gallardo y Prat presentan una serie de 55 adenosarcomas, de los cuales 5 causaron la muerte de la paciente5. Se han descrito varios casos más.
En nuestro caso, la paciente presentó una óptima respuesta al tratamiento y en la actualidad (5 años después), se mantiene sin signos de recidiva ni de enfermedad.
Responsabilidades éticasProtección de personas y animales. Protección de personas y animales. Los autores declaran que para esta investigación no se han realizado experimentos en seres humanos ni en animales.
Confidencialidad de los datos. Los autores declaran que han seguido los protocolos de su centro de trabajo sobre la publicación de datos de pacientes y que todos los pacientes incluidos en el estudio han recibido información suficiente y han dado su consentimiento informado por escrito para participar en dicho estudio.
Derecho a la privacidad y consentimiento informado. Los autores han obtenido el consentimiento informado de los pacientes y/o sujetos referidos en el artículo. Este documento obra en poder del autor de correspondencia.
Conflicto de interesesLos autores declaran no tener ningún conflicto de intereses.